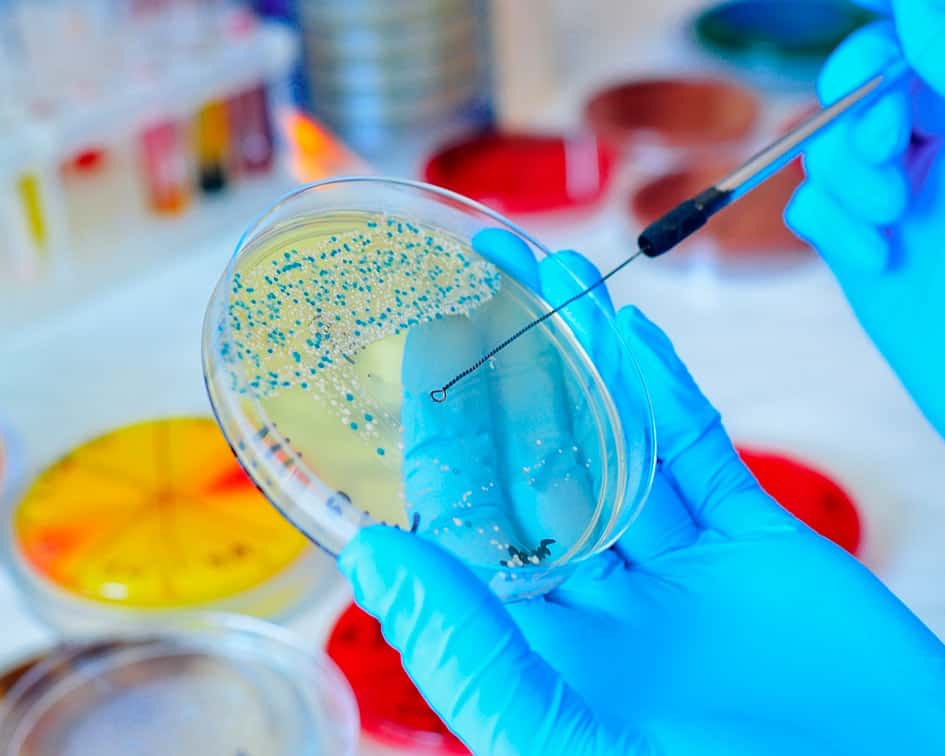

Avisos e actas da avalición do Proxecto Intermodular.
- Profesor/a: Mª Isabel Fernández Fernández
- Profesor/a: Juan José Varela Abeledo
- Profesor/a: Daniel Gómez Brañas
- Profesor/a: Lucía Vidal
Módulo do ciclo formativo Laboratorio clínico e biomédico da familia de Sanidade.
Aborda contidos relativos ás características específicas de seguridade no Laboratorio de microbioloxía. Describe os procedementos e técnicas comúns no estudo das bacterias, centrados no ámbito da clínica.
Estuda tamén as identificacións máis importantes no campo da Micoloxía, Parasitoloxía e Viroloxía.
Trátase de adquirir coñecementos básicos para comprendelas técnicas e procedementos precisos para a vida laboral do alumnado futuros técnicos superiores, tendo sempre en conta que é un sector en constante cambio no que a evolución técnica é unha realidade cotiá.
- Profesor/a: Mª Isabel Fernández Fernández
Este módulo profesional contén a formación necesaria para desenvolver as funcións de realizar análises bioquímicas en mostras biolóxicas, pódese considerar dividido en duas grandes partes, na primeira estudaranse as principais técnicas instrumentais empregadas no LCB e a segunda é a parte mais propiamente correspondente ás análises bioquímicas.
Esta función abrangue aspectos como:
Selección da técnica.
Posta a punto dos equipamentos.
Preparación de reactivos.
Validación técnica do resultado.
As actividades profesionais asociadas a esta función aplícanse en:
Laboratorios de análises clínicas hospitalarios e extrahospitalarios, laboratorios de institutos de toxicoloxía, de investigación biosanitaria, de toxicoloxía, de clínicas veterinarias e, de xenética clínica e diagnóstico prenatal.
Centros de reprodución asistida.
As liñas de actuación no proceso de ensino e aprendizaxe que permiten alcanzar os obxectivos do módulo han versar sobre:
Identificación da técnica segundo a magnitude que cumpra analizar.
Interpretación de protocolos.
Calibración dos equipamentos.
Determinación de magnitudes bioquímicas en mostras biolóxicas.
Realización e valoración do control de calidade analítico.
Aplicación das normas de calidade, seguridade, saúde laboral e protección ambiental.
- Profesor/a: Juan José Varela Abeledo
Este módulo contén a formación para realizar análises hematolóxicas en mostras biolóxicas humanas e procedementos de obtención de hemoderivados. Abrangue aspectos como:
– Preparación e exame de extensións de sangue e de medula ósea ao microscopio óptico.
– Manexo de aparellos automáticos de análise hematolóxica.
– Aplicación de técnicas para o estudo da hemostasia e da coagulación.
– Preparación e distribución de hemoderivados.
– Aplicación de técnicas inmunohematolóxicas para garantir compatibilidades entre doador/a e receptor/a.
- Profesor/a: Eva Buján
- Profesor/a: Mª Peregrina Varela Caamiña